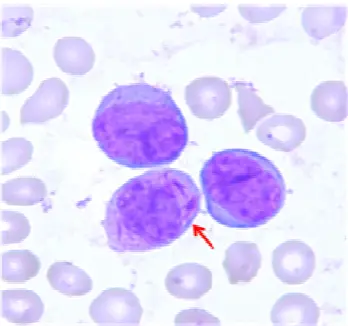
圖片

106年:(醫檢)血液(2)
箭頭所指的細胞有特殊的細胞質內涵物( inclusion ),呈現一捆棒狀物的樣子,這種細胞稱為:
Afaggot cell
Bsmudge cell
CChédiak-Higashi syndrome cell
DMay-Hegglin anomaly cell
詳細解析
本題觀念:
本題考察血液抹片中具有特殊細胞質內涵物的白血病細胞辨識。題目要求識別箭頭所指細胞,其細胞質內含有一「捆棒狀物」(bundle of rod-like inclusions),此即 faggot cell 的典型形態特徵,為急性前骨髓細胞性白血病(acute promyelocytic leukemia, APL)的高度特異性血液學所見。
影像分析:
血液抹片(Wright-Giemsa 染色)的背景可見大量正常紅血球(粉紅色、雙面凹形)。抹片中央可見 3 顆大型細胞,細胞質豐富、深紫色,核形呈腎形或雙葉狀(bilobed),為前骨髓細胞(promyelocyte)的特徵。紅色箭頭所指的細胞(右下方)細胞質內可清楚辨識出多根棒狀結構(Auer rods)堆疊成束,形如「一把木柴」,即所謂的「faggot cell」(束狀 Auer 桿細胞)。此細胞與其他兩顆前骨髓細胞(左側及上方)相比,細胞質中的棒狀內涵物更為密集明顯。此影像高度符合急性前骨髓細胞性白血病(APL, FAB M3)的形態學特徵。
選項分析
(A) faggot cell 正確。Faggot cell(束狀 Auer 桿細胞)是含有 3 根或以上 Auer rods 並堆疊成束的異常前骨髓細胞,其外觀猶如「一捆柴火(a bundle of sticks/faggo
...(解析預覽)...

升級 VIP 解鎖圖文解析